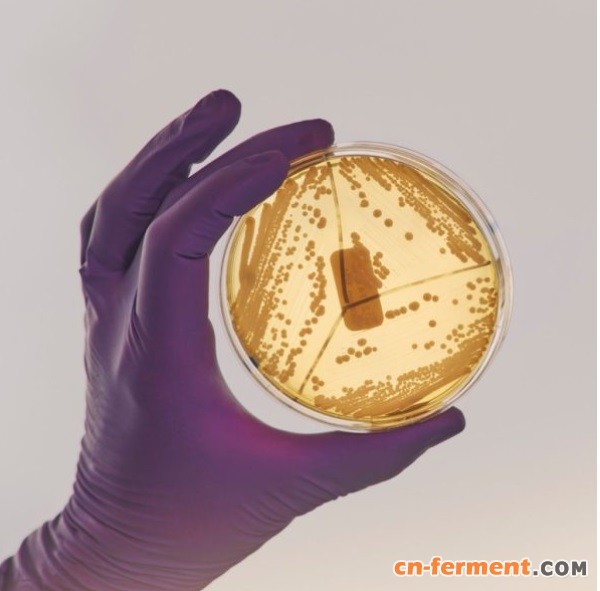
2

01 债务总额高达13亿美元Amyris什么时候开始崩盘的?
WWD报道显示,日前,Amyris已向特拉华州法院申请破产保护,Amyris在美国以外的公司不包括在此次破产程序中。作为收购过程的一部分,Amyris已从现有贷款机构Foris Ventures获得1.9亿美元的债务人持有融资,以支持其持续的日常运营。法庭文件显示,其债务总额高达13亿美元。
据了解,公司的此次重组旨在改善成本结构、资本结构和流动性状况,同时精简Amyris的业务组合,专注于研发核心能力以及通过生物发酵衍生的可持续成分的规模化、商业化和应用开发。
与此同时,为了推进公司的重组目标并实现资产价值最大化,Amyris计划退出其消费品牌经营并开始将品牌进行销售,以期让这些品牌在新的所有权下,继续利用Amyris的科学和技术。
“在过去的几个月里,我们一直在努力制定一项战略转型计划,以降低成本,提高运营效率,实现可持续增长,”Amyris临时首席执行官兼首席财务官Han Kieftenbeld在提交的文件中表示。“我们相信,我们公司今天迈出的这一步使我们走上了应对财务挑战的最佳道路,并实现了一个全面的解决方案——植根于Amyris突破性的科学、配方能力和技术。”
Amyris的破产其实早有征兆。
就在宣布这一消息的几天前,Amyris关闭了三个品牌——与前卡尔文·克莱因设计师弗朗西斯科·科斯塔合作的Costa Brazil、Naomi Watts和与Purecane共同创立的onda Beauty,并裁去了260个职位。
而在过去的一年内,Amyris的股价已下跌74%,年内股价下跌近60%。截至发文时间,Amyris的总市值已跌至2434.25万美元,股价跌至0.066美元/股。
今年6月,Amyris宣布John Melo已辞去总裁、首席执行官兼董事会成员的职务,该公司董事会已任命Han Kieftenbeld为临时首席执行官,他还将继续担任该公司的首席财务官。与此同时,该公司还宣布将在全球范围内裁员,进一步实现削减成本的目标。
今年5月,Amyris公布的 2023 年第一季度的财报显示,其经营形势依旧呈下滑状态。
一方面,Amyris“连续七个季度实现创纪录增长”的消费者收入同比下降,而消费者收入一直是其核心收入增长的主要部分,管理层将此归咎于缺乏营销支出;另一方面,即便调整了最近收购的EcoFabulousTM品牌有关的420万美元库存注销后,Amyris毛利率依旧是负值。
该季度财报还显示,Amyris的未偿债务本金增至9.62亿美元,创下历史新高。
Amyris是如何一步一步滑入“深渊”的?
Amyris于2003年成立,总部位于美国加州。作为合成生物学市场的开山鼻祖,Amyris在成立早期就取得了十分亮眼的成果,由于做出利用微生物合成青蒿酸(artemisinic acid,合成青蒿素的重要前体)的亮眼成绩,Amyris成功成为合成生物学领域的第一家纳斯达克上市公司。

2010年,Amyris在美国纳斯达克股票交易所上市,股价一度飙升至34美元/股,与如今的0.066美元/股形成鲜明对比。初涉资本市场并历经短暂的辉煌后,公司股价随即出现大幅波动,主因是新产品的大规模生产面临困境。
为了扭转困境并获取实际的收益,Amyris将其明星产品“法尼烯”,经一步简单的转化合成一种叫做角鲨烯的成分,再经去氢处理后,得到一种性质更加稳定的角鲨烷。
角鲨烷具有高度的亲肤性和稳定性,获得护肤界的高度青睐,号称“护肤万金油”,且比起传统的角鲨烯提炼方式,合成角鲨烷更环保、可持续。在该业务线上,公司和欧莱雅、雅诗兰黛、亿帆医药等知名厂家都建立了合作。可以说,合成角鲨烷对于Amyris扭转困局具有重要意义。
今年4月4日奇华顿宣布,已完成对Amyris的主要化妆品成分组合的收购,据奇华顿在2022年的业绩推算,Amyris的活性化妆品成分业务将为奇华顿带来约3000万美元的增量销售(按预估值计算),然而这不是一个很理想的数字。
与此同时,Amyris近年来的经营状况也并不好。
财报数据显示,2022年,Amyris全年营收2.7亿美元,同比2021年的3.4亿下滑了21%。2023年一季度,Amyris营收5608.3万美元,同比2022Q1的5770.9万美元,下降了2.8%,该季度的亏损达到了创纪录的2.02亿美元,同比去年1.1亿的亏损几乎翻倍。
02 “科学家做生意”,经营问题是绕不过的难关
事实上,Amyris是国外少有的几家将生意盘做大的合成生物公司。
《FBeauty 未来迹》在《从风口看未来,中国合成生物企业正处于“落地”关键期 | 生物纪⑤》一文中做过梳理,国外的合成生物企业起步早于国内,目前涉及化妆品领域的海外合成生物企业主要有Amyris、GETLOR、LYGOS等6家企业。

这类企业多以中小型研发型企业为主,主要做B端原料生意。而Amyris是少有的既做B端又做C端的企业,其市值规模也处于海外前列。
此前,美国合成生物企业Zymergen于2016年至2020年获得总共8.3亿美元融资,但因经营不善、长期亏损,于2022年被Ginkgo收购。Zymergen和Amyris一样,都是经营出现问题导致长期亏损。
大部分合成生物企业的创始人都是拥有相关学科研究背景,让“科学家做生意”,经营问题仿佛成为绕不过的难关。而Amyris的“死结”,就在于难以平衡化妆品品牌的经营与原料研发生产业务。
根据恒州博智调研发布的《2022年全球角鲨烷(烯)行业调研及前景分析(简报)》,就全球来看,角鲨烷(烯)原料供应集中度并不高,Amyris,Sophim,Croda,Kishimoto,EFP和VESTAN是全球主要的供应商,其中Amyris是全球最大的供应商,估计其占据41%的市场份额。
“Amyris在合成角鲨烷原料上其实是成功的。”百氪生物科技销售总监胡鹏认为,Amyris是全球唯一一家角鲨烷发酵来源,同时也是唯一一家实现量产的,一年大概有2000吨销量。
除去合作伙伴外,Amyris的10大客户已经占据了90%的收入。对于角鲨烷这种高端产品而言,基本上绝大部分的产品均被顶级的化妆品公司或者香精公司所预定,其供应链条十分稳固。
尽管Amyris在角鲨烷领域表现得十分强劲,但一位资深业内人士表示:“Amyris还未在角鲨烷这个原料品类里做到最强最扎实、非它不可。”
而Amyris近年来也并没有继续提升原料方面的优势,而是转头不断加大化妆品品牌业务方面的投入,且尚未得到相应的回报。自从Amyris开始经营化妆品品牌相关业务,企业就仿佛走向了一条不断投入的“不归路”。
Amyris旗下品牌Biossance
Amyris的产品业务并非没有过增长,从其披露的2020 Q3财报数据可以得知,在清洁美容等消费领域,Amyris的毛利率已经达到了67%,其当季产品收入相比同期增长了220%。
尝到了在消费产品(清洁美容)领域的甜头后,Amyris又于2021年拟定了一系列“品牌打造”计划,如在2021 Q2推出专门针对脸部痤疮的护肤品牌Terasana;2021 Q3 推出彩妆品牌Rose和护发清洁品牌JVN。
Amyris的目标,是占领80%的全球美容和个人护理市场。Amyris一位高管此前曾在公开采访中表示,“我们是最终产品的卖方。Amyris会将公司打造成为产品公司,而不是技术许可公司。”
但遗憾的是,Amyris从原料公司成为消费品公司的转型之路走得并不顺利。
根据Amyris2022年第三季度财报,从消费业务收入来看,Amyris2022年Q3为4656万美元,相比去年同期增幅达到了98%,创造了历史新高。虽然在业绩上取得了将近翻倍的成绩,但其销售成本高增最终导致亏损,财报显示,Q3期间销售成本高达1.25亿美元,相比去年同期的增幅达到了惊人的77%。
在销售成本增长的基础上,销售额却没有同比增长,销售成本增加的5407万美元也仅仅使得收入增加了2326万美元。这也导致资本市场对其持续盈利能力产生了极大的怀疑,股价直线下跌。
而根据Amyris2022年公司的电话会议透露,其在巴西工厂已经投入了近1亿美元,投资巨大但进展缓慢。最终,Amyris的债务不断堆积,走向破产重组之路。
“根本原因还是创始人没有商业经验,他们都是科研人员。”胡鹏认为,Amyris走到今天这一步,在经营重心的方面问题很大,公司在还没抓稳原料研发优势的情况下,就大举扩张至消费品领域,这未免有些操之过急。
据了解,在申请破产重组前,Amyris旗下已经拥有约14个不同类别的品牌,囊括纯净美妆、香氛和健康三个方向。而在2003年刚成立由Jay Keasling等科学家联合创办成立时,公司最初的愿景是利用合成生物学技术,解决生产青蒿素和其他萜类化合物过程中的问题。
Amyris旗下品牌JVN
显然,对于Amyris的创始团队——一群科学家而言,管理14个不同类别的品牌的确不是一件简单的事情。
Amyris也意识到了这一点,在此次破产重组中也明确指出,将精简Amyris的业务组合,专注于研发核心能力以及通过生物发酵衍生的可持续成分的规模化、商业化和应用开发,并计划将旗下现有品牌进行销售。
03 前车之鉴,Amyris带来哪些启示?
Amyris的诞生背景其实和国内大多数合成生物企业较为相似,都是由具有相关科研背景的科学家创立。且近年来,国内合成生物赛道还刮起一阵阵投融资风潮。
从2022年巨子生物完成了融资规模达73.3亿元的Pre-IPO轮融资随后成功在港交所上市,到蓝晶微生物近两年融资总额逼近20亿。虽然起步较晚,但国内合成生物企业在成果转化和商业运作能力上要更胜一筹,从企业营收和市值的角度来看,国内合成生物企业在资本领域拥有更强的议价能力,企业市值大多在年营收10倍以上。

不过,风口过后,合成生物企业同样要面对后续经营及业绩增长难题。当走在前列的外资合成生物企业Zymergen和Amyris都倒在了经营上,这对国内同行有何启示意义?
首先,需要明确的是,国内合成生物企业与国外企业其实有较大差别。
其中最突出的一点便是成长路径不同,相较于海外合成生物企业偏爱高附加值的创新技术研究,国内合成生物企业会更“务实”,倾向于优先解决“吃饭”问题,常常去选择一些相对热门,变现周期短,转化程度高,门槛略低的方向进行研发。这也导致少国内合成生物企业扎堆在重组胶原蛋白、依克多因等特定成分领域。
通过价格优势获得市场的主导权,并直接布局C端市场,让企业拥有更强的盈利能力。与此同时,以市场驱动科研转化,技术突破,在这样的过程中,国内合成生物企业在拥有更强生产能力的同时,也在不断深挖自己的技术护城河。
所以,Amyris的境遇有其自身的特殊性,并不能简单将其经历投射在国内企业身上。
不过,Amyris在其经营路径及原料选品方面具备一定借鉴意义。“专注其实非常重要。”胡鹏认为,不论是专注某一原料领域或是某项产品业务,企业都应学会专注。Amyris在团队没有相关商业经营经验的情况下,盲目加大对于化妆品品牌业务的投入,是一种冒险。
相关资深业内人士也持有相同看法:“本来To B企业做To C的生意就算是跨行了,让一个科学家去‘卖货’,这条路跑通需要时间,也需要交够学费,没撑过去就没办法了。”
另一方面,Amyris还未在其核心原料角鲨烷上形成绝对的价格或者性能上的优势。上述业内人士表示,目前,角鲨烷行业还处在较为分散的状态,Amyris在B端的生意本身也存在竞争,并不会因为它是一家合成生物企业就比传统原料企业更有优势。
与此同时,角鲨烷的同类原料也很多,同样的成本可以用其它便宜的保湿剂组合,来达到更好的性能。上述业内人士认为:“在角鲨烷的价格区间里,它并不是这类原料里面的最优解。”这其实也在提醒其他合成生物及原料企业,原料选品其实非常重要,有技术不代表能把技术变成市场,很多时候,原料的市场天花板也决定了企业的天花板。
最后,Amyris的经历其实能给大热的合成生物赛道在某种程度上“降降温”。很多时候,合成生物企业都需要遵循大部分行业的发展规律,Amyris所代表的一些经营难题其实是客观存在的,在前期获得融资之后,如何经营、创造经济增长点、提升核心原料竞争力等,都是需要深入去挖掘的课题。
“Amyris的遭遇其实还是挺令人惋惜的。”胡鹏表示,Amyris前期发展其实遇到了很多困难,如今走向破产重组,不免令人唏嘘。但他认为,在经历破产重组之后,也就是原料生物与化妆品品牌生意剥离之后,Amyris其实还有“东山再起”的可能。
Amyris临时首席执行官兼首席财务官Han Kieftenbeld
根据Han Kieftenbeld致Amyris员工的邮件,通过重组,Amyris主要寻求实现三件事,其中一件便是围绕核心技术平台和原料业务集中开展业务,精简业务组合,以专注于研发核心竞争力。Han Kieftenbeld在邮件中写到:“我想说清楚的是,我们的目标是成为业界最高效、最具生产力的生物技术公司,这一点并没有改变。”
对于现有的消费品牌,Han Kieftenbeld在邮件中表示:“我们为这些清洁美容品牌在市场上产生的影响以及帮助满足对可持续、有效和可获取产品日益增长的需求而感到自豪。同时,我们预计,在新的所有权下,这些品牌的全部价值将进一步释放出来,这也是我们决定在 Amyris之外为它们寻找新家的原因之一。”
很明显,Amyris在布局C端市场上交了“巨额学费”,而在破产重组之后,市场也有理由期待它的“蜕变重生”。



















































